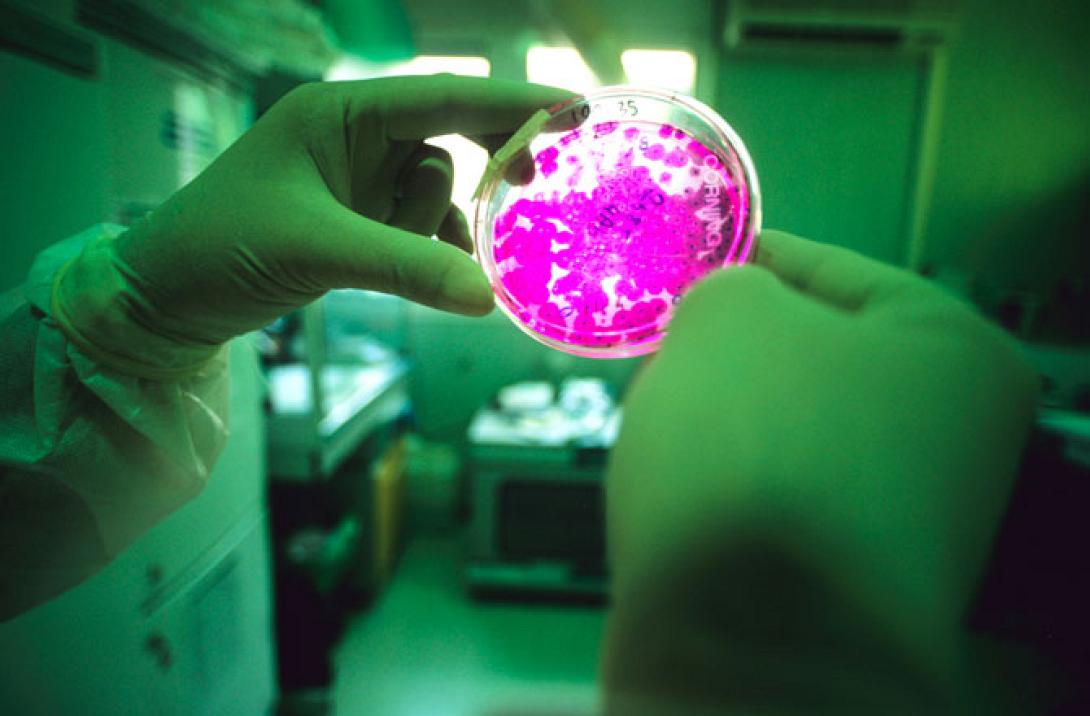
'Εφτιαξαν ανθρώπινο στομάχι με τη βοήθεια βλαστοκυττάρων!

Επιστήμονες στις ΗΠΑ - μεταξύ των οποίων μία ελληνικής καταγωγής- κατάφεραν για πρώτη φορά, με τη βοήθεια πολυδύναμων βλαστικών κυττάρων, να δημιουργήσουν στο εργαστήριο ένα λειτουργικό τρισδιάστατο ιστό ανθρώπινου στομαχιού. Σε πρώτη φάση το νέο επίτευγμα στο πεδίο της αναγεννητικής ιατρικής θα βοηθήσει στην καλύτερη μελέτη των διαφόρων ασθενειών που αφορούν το στομάχι και στην ανάπτυξη νέων φαρμάκων.
Οι ερευνητές του Ιατρικού Κέντρου και του Νοσοκομείου Παίδων του Πανεπιστημίου του Σινσινάτι, με επικεφαλής τον αναπτυξιακό βιολόγο Τζιμ Γουέλς, που έκαναν τη σχετική δημοσίευση στο περιοδικό "Nature", σύμφωνα με το ίδιο και το "Science", ανακοίνωσαν ότι ήδη χρησιμοποίησαν το μίνι εργαστηριακό στομάχι (που αποκαλείται και «γαστρικό οργανοειδές») για να μελετήσουν τη λοίμωξη από το ελικοβακτηρίδιο του πυλωρού (H.pylori), μία βασική αιτία του έλκους και του καρκίνου του στομάχου. Οι επιστήμονες δήλωσαν εντυπωσιασμένοι από το πόσο γρήγορα ο παθογόνος μικροοργανισμός μόλυνε τον επιθηλιακό ιστό του στομαχιού, ενώ ενεργοποίησε και ένα γονίδιο (c-Met) που προκαλεί καρκίνο.
«Μέχρι τώρα κανείς δεν είχε ποτέ παράγει γαστρικά κύτταρα από ανθρώπινα πολυδύναμα βλαστικά κύτταρα. Επιπλέον, ανακαλύψαμε πώς να προχωρούμε στον σχηματισμό τρισδιάστατου γαστρικού ιστού με πολύπλοκη αρχιτεκτονική και κυτταρική σύνθεση» δήλωσε ο Τζιμ Γουέλς.Μέχρι τώρα, οι επιστήμονες αρκούνταν στην μελέτη πειραματόζωων (ποντικιών), των οποίων όμως το στομάχι διαφέρει από το ανθρώπινο.
Οι επιστήμονες θα χρησιμοποιήσουν πλέον αυτά τα μίνι ανθρώπινα στομάχια για να«ξεκλειδώσουν» περαιτέρω τα μυστικά του ανθρώπινου στομαχιού. Μεταξύ άλλων, θα μελετήσουν καλύτερα τις βιοχημικές διαδικασίες, εξαιτίας των οποίων η παχυσαρκία τροφοδοτεί τον διαβήτη και το μεταβολικό σύνδρομο.
Το μίνι στομάχι χρειάστηκε περίπου ένα μήνα για να αναπτυχθεί στο εργαστήριο και να φθάσει τα τρία χιλιοστά σε διάμετρο και μέγεθος μικρότερο από μπιζέλι. Η ανάπτυξη του μικροσκοπικού οργάνου μπορεί να γίνει με αφετηρία τόσο εμβρυικά βλαστικά κύτταρα, όσο και σωματικά κύτταρα (του δέρματος) που έχουν αναπρογραμματιστεί σε πρώτη φάση για να γίνουν πολυδύναμα - βλαστικά και μετά μετατρέπονται σε γαστρικά.
Ο τελικός στόχος είναι να αναγεννάται στο εργαστήριο πλήρης στομαχικός ιστός που θα αντικαθιστά τα κατεστραμμένα σημεία του φυσικού στομαχιού του ασθενούς λόγω έλκους. Ήδη η ερευνητική ομάδα του Τζιμ Γουέλς άρχισε να δοκιμάζει τη χρήση των μικροσκοπικών στομαχικών ιστών του εργαστηρίου για να «μπαλώσει» τρύπες στο στομάχι πειραματόζωων(ποντικιών).
Στην έρευνα συμμετείχε η Γιάννα Ζαβρού, επίκουρη καθηγήτρια του Τμήματος Μοριακής και Κυτταρικής Φυσιολογίας του Πανεπιστημίου του Σινσινάτι.
Και άλλα όργανα μέχρι σήμερα έχουν αναπαραχθεί στο εργαστήριο, όπως νεφρά, ήπαρ και- πιο πρόσφατα- έντερο.
Πηγή: ΑΜΠΕ